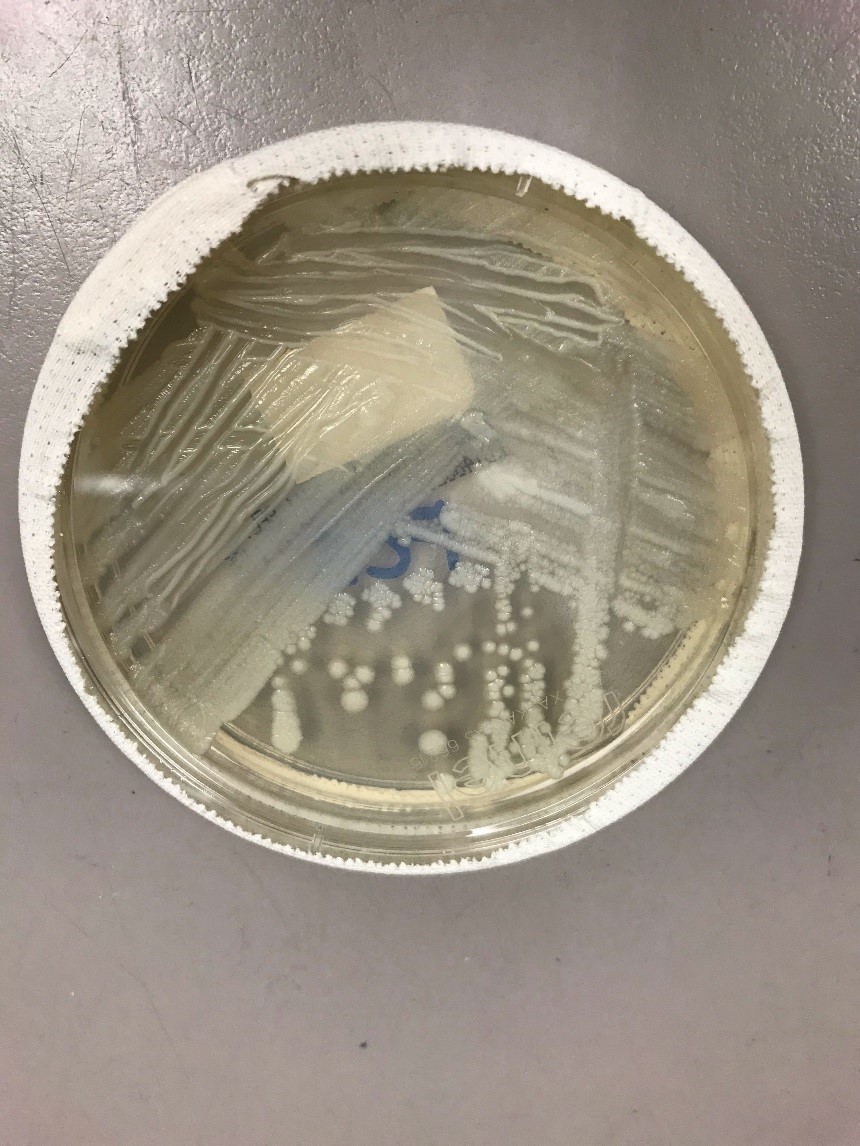

Case History
A 35 year old female with a history of BRCA-positive breast cancer (status-post right radical mastectomy February 2018) underwent prophylactic left mastectomy and revision of right mastectomy. She received prophylactic clindamycin and cefazolin. She was discharged on post-op day 5 with bacitracin and 3 weeks of cefadroxil. She initially healed well. On post-op day 43 she noted drainage from the left incision site. At presentation she was afebrile. There was a 3.0 x 2.0 cm area of induration and erythema on the right lateral aspect of her abdominal incision with seropurulent drainage. Incision and drainage was performed in office and a swab of the fluid was sent to microbiology. The initial gram stain and cultures were negative for bacteria. The patient was placed on sulfamethoxazole-trimethoprim and levofloxacin. At follow up 7 days later, another abscess was medial to the prior site was incised and drained. A swab of the fluid was sent to microbiology for bacterial and fungal cultures.
Laboratory Identification
Fungal cultures grew at 36 hours on potato-flake agar. Gram stain revealed gram-variable bacilli. Growth on 7H10 agar produced colonies at 72 hours, and Kinyoun staining was positive for acid-fast bacilli. Matrix assisted laser desorption ionization-time of flight mass spectrometry (MALDI-TOF) at 72 hours identified Mycobacterium abscessus complex.

Discussion
M. abscessus complex is a group of rapidly-growing, nontuberculous mycobacteria. As such they are acid-fast bacilli that grow within 7 days when transferred from solid media to solid media. The subspecies are M. abscessus abscessus, M. abscessus massiliense, and M. abscessus bolletii. The complex is known to cause progressive pulmonary disease in patients with underlying structural lung diseases. It has been estimated to comprise up to 13% of all mycobacterial pulmonary infections. It has also been implicated in skin and soft tissue infections (SSTIs) following surgical procedures or environmental exposure (i.e. spas). SSTIs can also occur by seeding from disseminated disease. Rarer manifestations include central nervous system (CNS) and ocular involvement. Identification is by culture and molecular techniques. It is classically resistant to many drug classes with limited consensus on appropriate therapy. It can harbor the erm gene, which confers inducible erythromycin resistance. Clarithromycin, amikacin, and cefoxitin tend to have the lowest rates of resistance. Long-term multidrug regimens are recommended, based on susceptibility testing. Changes to initial therapy are usually required due to side effects or lack of efficacy. Surgical therapy is often required, when possible. Mortality post therapy is approximately 15%.
At two-week follow up, the wound had no purulent drainage or erythema. The plan was for prolonged three-drug therapy tailored to susceptibility data.
- Griffith DE. Rapidly growing mycobacterial infections: Mycobacteria abscessus, chelonae, and fortuitum. Von Reyn CF and B A, eds. UpToDate. Waltham, MA: UpToDate Inc. https://www.uptodate.com (Accessed on May 21, 2019.)
- Lee MR, Sheng WH, Hung CC, Yu CJ, Lee LN, Hsueh PR. Mycobacterium abscessus Complex Infections in Humans. Emerg Infect Dis. 2015;21(9):1638–1646.
- Novosad SA, Beekmann SE, Polgreen PM, et al. Treatment of Mycobacterium abscessus Infection. Emerging Infectious Diseases. 2016;22(3):511-514.
-Jonathan Wilcock, MD is a 1st year anatomic and clinical pathology resident at the University of Vermont Medical Center.

-Christi Wojewoda, MD, is the Director of Clinical Microbiology at the University of Vermont Medical Center and an Associate Professor at the University of Vermont.
Hi Jonathan, when you guys found colonies were acid-fast positive, did you add some extra procures to proceed the maldi-tofms in case they’re real tb bugs and to spread in the lab or you guys use the specific maldi for tb only? cheers, michael